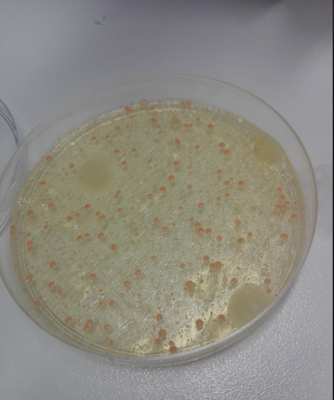

martes, 20 de junio de 2017
Prensa neumática
Bueno en estas entrada os voy a enseñar lo que hemos hecho en la clase de tecnología, hemos empezado a trabajar con los kits de neumática que funcionaba al bombear un pulsador que venía dentro del kit, en el cual dentro venían unas cuantas prácticas para realizar por equipos, el mio estaba compuesto por Alejandro y Kaela.
Esta práctica consistía en crear una prensa con dos movimientos.
Esta práctica consistía en crear una prensa con dos movimientos.
Ascensor de tijera neumática
Bueno en estas entrada os voy a enseñar lo que hemos hecho en la clase de tecnología, hemos empezado a trabajar con los kits de neumática que funcionaba al bombear un pulsador que venía dentro del kit, en el cual dentro venían unas cuantas prácticas para realizar por equipos, el mio estaba compuesto por Alejandro y Kaela.


Este es el resultado ya todo montado.



Este es el resultado ya todo montado.

PBL
En esta entrada os voy a explicar en qué consistía el último PBL que hemos hecho en matemáticas.
El PBL consistía en hallar la longitud,la capacidad y el dinero que costaría llenar una piscina con Coca-Cola.
En primer lugar realizamos una rutina de veo, pienso y me pregunto.
Veo
-Una piscina de Coca-Cola.
Pienso
Pienso que se pueden permitir gastar demasiado dinero
Me pregunto
-¿Qué capacidad tendrá la piscina?
-¿Cuántos litros habrá dentro?
Después realizamos una estimación de cuantas botellas habría usado y de cuanto dinero se habría gastado, mi estimación fue la siguiente.
Botellas - 80 lo que equivaldrían a 160 litros
Dinero - 400 euros.
Más tarde para sacar cuanto era la longitud de la piscina el profesor nos paso una foto con las medidas de la piscina.
Capacidad de la piscina - 12ft x 30pulgadas.
A partir de aquí realizamos las conversiones.

Y vimos que un pie son 0,3048 metros, y una pulgada son 0,0254 metros o lo que es lo mismo 2,54 cm.
Tras realizar la conversión sacamos el volumen a partir de la fórmula área de la base x altura y el radio del cilindro.
Sabiendo a lo que equivalía un pie (0,3048m) y 12 pies equivalían a 3,6576² debíamos multiplicarlo por pi (3,14) para así hallar el radio del cilindro.Y así el radio nos salió 42,0027 metros.
En segundo lugar calculamos cuantos litros y cuantas botellas serían los que había dentro de la piscina,para hallar esto debimos multiplicar 3,14 x el radio² y por la altura.

Realizando los cálculos al resolverlo nos salieron 8200 litros, lo que correspondería a 4000 botellas contando que cada botella de 2 litros son 1 euro, las botellas habrían costado 4100 euros. Por último calculamos el espacio vacío calculando el espacio vacío de un cilindro de 25 cm.

Todo esto lo he hecho con la ayuda de mis compañeros de clase, la explicación del profesor sobre el PBL y los datos que se nos proporcionaron para resolverlo,debéis saber que a partir de este PBL he aprendido a hallar el volumen de una piscina cilíndrica,y cual es la conversión de 1 pies y una pulgada a metros y esto lo he aprendido atendiendo a la explicación del profesor.
Si os soy sincero creo que no ha habido nada que me haya costado demasiado por lo tanto de volver a hacerlo lo haría igual ya que estoy contento con el resultado pero si tuviese que destacar un momento sería el momento en el cual sacamos el precio y las botellas que serían ya que fue sorprendente porque nadie tenía nada parecido en la estimación.
Sin duda creo que esto se puede aplicar a la vida real y más ahora que llega el verano ya que a quien no le gustaría saber que capacidad y volumen tiene su piscina...Ya que así se sabe cuantas personas entran dentro y cuantos litros debes usar para llenarla.
En primer lugar realizamos una rutina de veo, pienso y me pregunto.
Veo
-Una piscina de Coca-Cola.
Pienso
Pienso que se pueden permitir gastar demasiado dinero
Me pregunto
-¿Qué capacidad tendrá la piscina?
-¿Cuántos litros habrá dentro?
Después realizamos una estimación de cuantas botellas habría usado y de cuanto dinero se habría gastado, mi estimación fue la siguiente.
Botellas - 80 lo que equivaldrían a 160 litros
Dinero - 400 euros.
Más tarde para sacar cuanto era la longitud de la piscina el profesor nos paso una foto con las medidas de la piscina.
Capacidad de la piscina - 12ft x 30pulgadas.
A partir de aquí realizamos las conversiones.
Y vimos que un pie son 0,3048 metros, y una pulgada son 0,0254 metros o lo que es lo mismo 2,54 cm.
Tras realizar la conversión sacamos el volumen a partir de la fórmula área de la base x altura y el radio del cilindro.
Sabiendo a lo que equivalía un pie (0,3048m) y 12 pies equivalían a 3,6576² debíamos multiplicarlo por pi (3,14) para así hallar el radio del cilindro.Y así el radio nos salió 42,0027 metros.
En segundo lugar calculamos cuantos litros y cuantas botellas serían los que había dentro de la piscina,para hallar esto debimos multiplicar 3,14 x el radio² y por la altura.
Todo esto lo he hecho con la ayuda de mis compañeros de clase, la explicación del profesor sobre el PBL y los datos que se nos proporcionaron para resolverlo,debéis saber que a partir de este PBL he aprendido a hallar el volumen de una piscina cilíndrica,y cual es la conversión de 1 pies y una pulgada a metros y esto lo he aprendido atendiendo a la explicación del profesor.
Si os soy sincero creo que no ha habido nada que me haya costado demasiado por lo tanto de volver a hacerlo lo haría igual ya que estoy contento con el resultado pero si tuviese que destacar un momento sería el momento en el cual sacamos el precio y las botellas que serían ya que fue sorprendente porque nadie tenía nada parecido en la estimación.
Sin duda creo que esto se puede aplicar a la vida real y más ahora que llega el verano ya que a quien no le gustaría saber que capacidad y volumen tiene su piscina...Ya que así se sabe cuantas personas entran dentro y cuantos litros debes usar para llenarla.
viernes, 16 de junio de 2017
PBL
En esta entrada os voy a explicar en que consistía el nuevo PBL que hemos hecho en matemáticas.
El PBL consistía en lo siguiente: un vídeo en el que aparecía una persona que llenaba un recipiente con forma de prisma octogonal. En primer lugar realizamos un veo,pienso me pregunto sobre el vídeo.
-Veo:
un cubo con agua
-Pienso:
porque no echa el agua con mas potencia
-Me pregunto:
¿Cuánta capacidad tiene ese cubo?
¿Cuánto tiempo tardara en llenarse?
Antes de empezar con los cálculos nuestro profesor nos dijo que hagamos una estimación de nuestras preguntas, es decir, cuanto tardaría en llenarse del todo y cuanta agua cabe ahí.
Todo esto lo hicimos en la clase de matemáticas a partir del vídeo, lo que mas me ha costado era recordar lo que era la apotema, y el profesor nos explico que eran los triángulos de dentro del octógono. Yo he aprendido como calcular el tiempo que tarda en llenarse cualquier recipiente y también he aprendido a que 1 centímetro cúbico son 0,0338140227 OZ y aparte he aprendido como calcular el área de la base de un prisma octogonal(perímetro x apotema/2) ,esto lo he aprendido con lo que fue explicando nuestro profesor en clase ya que la mayoría no nos acordábamos, lo que más me ha costado ha sido hallar el área de la base ya que primera instancia no me acordaba de lo que era el apotema, pero al final si salió como esperaba por lo tanto de volver a hacerlo cambiaría que antes de agobiarme con estos ejercicios sería repasar algunas formulas algo que destacaŕia es el momento en el que descubrí cuanto tardaría en llenar el recipiente. Lo mejor de todo es que esto se puede aplicar en la vida real ya que siempre aproximamos cuanto se tardaría en llenar muchas cosas y con esto ya lo sabríamos con precisión.
Estimación:
Capacidad: 15 minutos
Tiempo: 10 litros
después nos dijo las medidas de cubo
Altura de 36,5 cm
Lado de 12,4 cm
Luego a partir de la fórmula, que es perímetro por apotema partido de 2 nos pusimos a calcular,lo primero era calcular el área de la base para después pasar 16 OZ a centímetros cúbicos, y que 1cm cúbico son 0,0338140227 OZ.
aquí esta el área de la base:
Pasada a centímetros cúbicos:
Tras hallar el área de la base debíamos calcular en cuanto tiempo se llenaba el prisma de agua,aquí tenéis los cálculos.
Por último vimos un vídeo sobre la caída del agua,del cual debíamos hallar el tiempo que tardaba el agua en caer,aquí tenéis los cálculos.
lunes, 5 de junio de 2017
Técnicas de Laboratorio de Biología
En esta entrada voy a explicar la experiencia y práctica que hemos hecho en el laboratorio, para esto hemos necesitado la ayuda de un sargento del ejército español.
La práctica consistía en crear colonias de bacterias, entonces lo que hicimos fue ponernos en parejas para así cada uno traer una marca diferente de yogur y ver como reaccionaría la colonia de bacterias en cada uno de estos yogurt, A esa práctica la intentamos con los siguientes elementos:
-Yogurt: producto lácteo que se obtiene de la fermentación bacteriana de la leche. En nuestro caso utilizamos uno no esterilizado.
-Placa de Petri: es un recipiente con forma redondeada que sirve para cultivar, observar o examinar diferentes aspectos de la biología. Para no confundir las placas las pusimos numero de grupo el número 5.
-Agar nutritivo: es un medio de cultivo que se utiliza para cultivar sobre todo bacterias.
-Guantes y bata: prenda que utilizamos para poder manipularlo todo sin transferir a los elementos limpios ningún tipo de bacteria, y la bata para no mancharnos.
-Asa de siembra: es un instrumento de laboratorio que se utiliza para introducir de manera segura la muestra que debemos meter en la placa de petri en este caso era yogur.
En primer lugar nos pusimos las batas y nos lavamos las manos y nos pusimos los guantes porque necesitábamos las máxima limpieza e higiene en la práctica nos colocamos con nuestras parejas yo iba con Luis y empezamos a escuchar la explicación de Julio mientras el Agar nutritivo se descongelaba ya que estaba congelado a una muy baja temperatura.
Julio nos explicó que no podíamos dejar abierto y expuesto el vidrio de las placas de Petri ya que si no podría recibir bacterias que se encontraran en el aire,por lo tanto nos explicaron entre los 2 todo paso por paso.
Paso 1: el yogurt y de este con la asa de siembra recoger líquido que hay en el yogurt y colocarlo en un lado de una de las placas de petri.
Paso 2: colocar el agar en el lado opuesto de la placa de donde estaba el yogurt.
Paso 3: cerrar la placa y remover con 2 dedos durante unos minutos para así conseguir que el agar y el líquido bacteriano se fusionen.
Paso 4: poner celo a las placas y dejarlo en reposo durante una semana.
Por último a la semana comprobarlo y observar el resultado final,del cual podéis ver una imagen aquí.
-Prueba en pomo de la puerta del baño: en esta imagen no se aprecian muy bien pero hay colonias que son transparentes que son de suciedad que tenemos en las manos por eso sale en la placa del baño y la del móvil.
Y al final este es el resultado después de dejarlo una semana aquí se pueden ver las colonias de color naranja son colonias lactobacillus que se han formado.
La práctica consistía en crear colonias de bacterias, entonces lo que hicimos fue ponernos en parejas para así cada uno traer una marca diferente de yogur y ver como reaccionaría la colonia de bacterias en cada uno de estos yogurt, A esa práctica la intentamos con los siguientes elementos:
-Yogurt: producto lácteo que se obtiene de la fermentación bacteriana de la leche. En nuestro caso utilizamos uno no esterilizado.
-Placa de Petri: es un recipiente con forma redondeada que sirve para cultivar, observar o examinar diferentes aspectos de la biología. Para no confundir las placas las pusimos numero de grupo el número 5.
-Agar nutritivo: es un medio de cultivo que se utiliza para cultivar sobre todo bacterias.
-Guantes y bata: prenda que utilizamos para poder manipularlo todo sin transferir a los elementos limpios ningún tipo de bacteria, y la bata para no mancharnos.
-Asa de siembra: es un instrumento de laboratorio que se utiliza para introducir de manera segura la muestra que debemos meter en la placa de petri en este caso era yogur.
En primer lugar nos pusimos las batas y nos lavamos las manos y nos pusimos los guantes porque necesitábamos las máxima limpieza e higiene en la práctica nos colocamos con nuestras parejas yo iba con Luis y empezamos a escuchar la explicación de Julio mientras el Agar nutritivo se descongelaba ya que estaba congelado a una muy baja temperatura.
Julio nos explicó que no podíamos dejar abierto y expuesto el vidrio de las placas de Petri ya que si no podría recibir bacterias que se encontraran en el aire,por lo tanto nos explicaron entre los 2 todo paso por paso.
Paso 1: el yogurt y de este con la asa de siembra recoger líquido que hay en el yogurt y colocarlo en un lado de una de las placas de petri.
Paso 2: colocar el agar en el lado opuesto de la placa de donde estaba el yogurt.
Paso 3: cerrar la placa y remover con 2 dedos durante unos minutos para así conseguir que el agar y el líquido bacteriano se fusionen.
Paso 4: poner celo a las placas y dejarlo en reposo durante una semana.
Por último a la semana comprobarlo y observar el resultado final,del cual podéis ver una imagen aquí.
-Prueba en pomo de la puerta del baño: en esta imagen no se aprecian muy bien pero hay colonias que son transparentes que son de suciedad que tenemos en las manos por eso sale en la placa del baño y la del móvil.
Prueba en pantalla de teléfono móvil:
Y al final este es el resultado después de dejarlo una semana aquí se pueden ver las colonias de color naranja son colonias lactobacillus que se han formado.
sábado, 3 de junio de 2017
Etnomusicología
En esta entrada hablare de lo que hemos hecho, para hablar de la música del mundo lo primero que hemos hecho es dividirnos en grupos y a cada grupo le tocaba explicar todo sobre músicas sobre algún lugar del mundo, mi grupo formado por Jacobo, Mirian, Cristian y Kaela nos tocó explicar sobre la música de África danzas, trajes, instrumentos.. para ello cada uno cogió algo que se centraría mas, yo decidí hacer los instrumentos, al tener en clase de música algunos que correspondían a los de África decidimos coger esos instrumentos y hacer una actividad para nuestros compañeros, ya que el hacer una actividad entraba en el proyecto, lo primero hemos terminado la presentación y luego hicimos una lluvia de ideas sobre que actividad hacer. Al final nos quedamos con una que nos gustó a todos y nos pareció interesante a la vez que divertida, la actividad (juego) irá de los siguiente, cada uno de los integrantes de mi grupo tendremos que tener un instrumento característico de África y tocar una canción conocida de la actualidad pero interpretada con estos instrumentos y los otros grupos tendrán que adivinar que canción es y el equipo ganador tendrá una recompensa.
Aquí dejo el enlace a nuestra presentación sobre África:
https://docs.google.com/presentation/d/12UgKXedZk8qxeC-9eWwjrEbbWKMacE8xlriFb4fO8nU/edit?usp=sharing
Y así son los cantos africanos:
Como se puede escuchar en el vídeo el principal instrumento suele ser el tambor y siempre lo acompañan con la voz y sus cantos tradicionales y con algún instrumento de percusión como el xilófono.
Aquí dejo el enlace a nuestra presentación sobre África:
https://docs.google.com/presentation/d/12UgKXedZk8qxeC-9eWwjrEbbWKMacE8xlriFb4fO8nU/edit?usp=sharing
Y así son los cantos africanos:
Como se puede escuchar en el vídeo el principal instrumento suele ser el tambor y siempre lo acompañan con la voz y sus cantos tradicionales y con algún instrumento de percusión como el xilófono.
miércoles, 31 de mayo de 2017
Robofuntion
En esta nueva entrada explicaré lo que hemos hecho en este proyecto, esta vez hemos
mezclado robótica con matemáticas, hemos empezado con las funciones y programamos
el robot para que siga una línea recta y una velocidad que coincida con el tiempo, todo
esto ha sido posible con Crumble que es una herramienta de programación, y para las gráficas
usamos la herramienta de Álgebra.
Este es nuestro robot con el que hacemos nuestras prácticas:
Todo esto lo hemos hecho siguiendo unas ciertas velocidades para poder ir probando las
velocidades del robot que eran estas:
ROBOFUNTION
Movimiento rectilíneo uniforme.
a) v= 0,02 m/s
b) v= 0,05 m/s
c) v= 0,1 m/s
d) v= 0,25 m/s
e) v= 0,5 m/s
f) v= -0,1 m/s
g) v= -0,25 m/s
al no saber a que porcentaje (velocidad) del robot teníamos que ir probando para que en una
cierta velocidad recorra los metros por segundos anteriores. Al final averiguamos la velocidad
para que cumpla esas medidas y grabamos los vídeos
Práctica 1
Práctica 2
Práctica 3
Práctica 4:
Práctica 5:
Nuestro robot debe esperar 3 segundos para empezar a moverse, si el analógico A es menor
que 20 el motor 1 irá a 41% y el motor 2 irá a 40% más la potencia de las otras ruedas,ya
que los tantos por ciento del motor se refiere a la potencia de las ruedas, en algunos casos
nuestro robot iba hacia el lado derecho entonces debíamos poner un poco mas de potencia
en la rueda izquierda.Y fue a partir de esto de lo que fuimos realizando las diferentes pruebas.
Aquí están todas nuestras prácticas:
-8 segundos/1,20 m
-1 segundo/1,15 m
- 2 segundos/30cm
- 3 segundos/45cm
Con todo esto he aprendido hacer gráficas con la herramienta de Geogebra que al principio
me costaba mucho porque no entendía muy bien el programa y como funcionaba pero con
ayuda de mis compañeros lo he podido hacer y al final lo he entendido, también he aprendido
a usar Crumble que para mí una aplicación desconocida y me ha parecido algo muy interesante
y muy útil. Todo esto lo he aprendido con ayuda de mi compañero Sergio que sabía mas de
Geogebra y es el que mas me ha ayudado para poder hacer las funciones sin muchos errores
y Crumble nos lo ha explicado nuestro profesor y ha sido mucho mas fácil todo después de su
explicación
¿Cómo lo he aprendido? Todo esto lo he aprendido gracias a las explicaciones de mis
compañeros y la del profesor, lo que mas nos ha costado en el grupo es llegar a la velocidad
del robot para que haga un determinado tiempo en una velocidad constante. Al final todo este
proyecto nos salió como esperábamos porque teníamos errores que se podían corregir y ahora
de volverlo a realizar lo único que cambiaría es apuntar desde un principio las velocidades que
hacía el robot.
viernes, 26 de mayo de 2017
TIC
En esta nueva entrada explicaré lo que yo he aportado a mi grupo, mi grupo esta compuesto por Raymi, Kilmer, Cristina y Pablo. Antes de crear nuestra app hicimos una lluvia de ideas para saber como vamos a diseñarla y sobre que tipo de maltrato se trataría, al final nos decidimos por crear una app contra la violencia de género que estaría camuflada por una app de period calendar. Al tener ya toda las ideas y el tema había que empezar con el diseño, para diseñar nuestra app cada uno de nosotros nos hemos repartido una tarea, yo con Cristina y Pablo hemos hecho los colores de nuestra app y ya empezamos a sacar las pantallas y al final nuestra app nos ha quedado muy bien y muy útil para todas las mujeres que sufren violencia de género. Al estar compitiendo con otros grupos hemos tenido que hacer un vídeo para poder vender bien nuestra app y este es nuestro video y nuestro guión.
Guión pitch
Estas son nuestras pantallas



Guión pitch
-Raimy: ¿Sabías que en este año 27 mujeres y 4 hijos han sido víctimas de la violencia de género?
-Kilmer: Con nuestro proyecto period calendar podemos ayudar a reducir el número de víctimas.
-Cris: Este proyecto es una app contra la violencia de género camuflada en una app de control hormonal femenino.
-Antony: Ayúdanos a salvar vidas invirtiendo en nuestra app.
-Pablo: Ni una sola víctima más por la violencia de género.
Estas son nuestras pantallas



miércoles, 19 de abril de 2017
Funciones
En esta entrada hemos realizado funciones con la hoja de cálculo pero antes lo hemos hecho en el cuaderno para saber como se representan y después en la hoja de cálculo ha sido mas fácil de representar todas las gráficas. Para poder saber como hacerlo antes hemos escuchado una breve explicación de como usar la hoja de cálculo. Al hacer todo esto he aprendido a usar mejor la hoja de cálculo y me ha quedado mas claro el tema de las funciones. Todo esto lo he aprendido fijándome en mis errores que tenía mas en la hoja de cálculo. Lo que mas me ha costado es hacer las funciones en la hoja de cálculo ya que al principio no lo entendía muy bien y siempre tenía algún error pero poco a poco los he corregido. De volverlo a repetir lo que cambiaría es prestar atención a la explicación para tener menos problemas a la hora de realizarlo solo.
lunes, 20 de marzo de 2017
Flamenco
El flamenco surge de las influencias de otras culturas que fueron coincidiendo en Andalucía. Sembrando semillas musicales y poéticas que fructificaron en su folclore, que ha sido el fundamento para crear otros estilos y la interpretación individual de algunos artistas. Evoluciona en espacios y reuniones familiares
1- Camarón tenía una voz llamada voz rota
2- Los instrumentos que siempre acompañan a este género son la guitarra, la caja y sobre todo las palmas
3- el ritmo casi siempre es el mismo un compás binario.
OrigenLos orígenes del flamenco empiezan en la parte sur de España (Cádiz, Sevilla y Almería), pero también se van implementando influencias árabes, cristinas, judías, pero sobre todo la gitana.
¿Cuáles son las características del baile flamenco? Hay muchas características, pero las que más destacan en este género son:
- El cante, es el canto andaluz con características gitanas.
- El toque, son los instrumentos o acciones que hagas para dar ritmo al baile.
¿Cuáles son las características del baile flamenco? Hay muchas características, pero las que más destacan en este género son:
- El cante, es el canto andaluz con características gitanas.
- El toque, son los instrumentos o acciones que hagas para dar ritmo al baile.
¿Qué significan la voz laina y la voz redonda? Voz laína: voz fina,delgada, muy aguda y brillante. Juan Breva es un ejemplo claro de este tipo de registro.
Voz redonda: voz dulce, armoniosa, sin bajos pero con agudos, y sobre todo viril. Tomás Pavón es un ejemplo de este tipo de voz.
Evolución de los instrumentos flamencosEl instrumento más utilizado en el flamenco es la guitarra, pero antes de incorporarse la guitarra, se las arreglaban con la pequeña percusión, y con la cuerda frotada, en la que utilizaban violines u otros instrumentos de cuerda como las vihuelas o las bandurrias, después de dos décadas aparece el cajón.
¿Qué son los palos flamencos?Los palos, son una forma de ordenar en subgrupos, los cantes que este arte ofrece, dependiendo de la región en el te encuentres, el cante es diferente.
Algunos de estos palos son: Fandango, Cantes camperos, Modismos y Cantes de compás.
Poéticos: estos son poemas cantados, que expresan el sentir del pueblo, están compuestos por tercetos, cuartetos y quintetos.
Armónicos: tienen acompañamiento melódico, la cadencia andaluza, la tonalidad mayor y menor, y por último las combinaciones armónicas.
Rítmicos: el ritmo más utilizado en el flamenco es la combinación de dos compases, el binario y el ternario.
Melódico: estas melodías se construyen sobre la base de escalas tonales (mayores y menores) y de la escala modal frigia (Modo de Mi).
Aquí dejo un esquema resumido del flamenco:
Esta es una canción muy famosa de flamenco, de Camarón de la isla
Voz redonda: voz dulce, armoniosa, sin bajos pero con agudos, y sobre todo viril. Tomás Pavón es un ejemplo de este tipo de voz.
Evolución de los instrumentos flamencosEl instrumento más utilizado en el flamenco es la guitarra, pero antes de incorporarse la guitarra, se las arreglaban con la pequeña percusión, y con la cuerda frotada, en la que utilizaban violines u otros instrumentos de cuerda como las vihuelas o las bandurrias, después de dos décadas aparece el cajón.
¿Qué son los palos flamencos?Los palos, son una forma de ordenar en subgrupos, los cantes que este arte ofrece, dependiendo de la región en el te encuentres, el cante es diferente.
Algunos de estos palos son: Fandango, Cantes camperos, Modismos y Cantes de compás.
Poéticos: estos son poemas cantados, que expresan el sentir del pueblo, están compuestos por tercetos, cuartetos y quintetos.
Armónicos: tienen acompañamiento melódico, la cadencia andaluza, la tonalidad mayor y menor, y por último las combinaciones armónicas.
Rítmicos: el ritmo más utilizado en el flamenco es la combinación de dos compases, el binario y el ternario.
Melódico: estas melodías se construyen sobre la base de escalas tonales (mayores y menores) y de la escala modal frigia (Modo de Mi).
Aquí dejo un esquema resumido del flamenco:
Esta es una canción muy famosa de flamenco, de Camarón de la isla
1- Camarón tenía una voz llamada voz rota
2- Los instrumentos que siempre acompañan a este género son la guitarra, la caja y sobre todo las palmas
3- el ritmo casi siempre es el mismo un compás binario.
Música española
Música española
En esta entrada os voy a explicar lo que hemos hecho en este tema.
Este trabajo lo hemos hecho con una breve explicación de la profesora sobre la música española.
Después hemos hecho un mapa mental sobre lo que nos explicó para que nos quedará mas claro.
A continuación, la profesora nos dio una lista de distintos compositores, donde teníamos que elegir uno para hacer una infografía con la aplicación de easel.ly.
Este trabajo lo he hecho con mi compañera Chizlette.
Nuestro trabajo se basaba en la vida y obra de Tomás Bretton
Este trabajo lo hemos hecho con una breve explicación de la profesora sobre la música española.
Después hemos hecho un mapa mental sobre lo que nos explicó para que nos quedará mas claro.
A continuación, la profesora nos dio una lista de distintos compositores, donde teníamos que elegir uno para hacer una infografía con la aplicación de easel.ly.
Este trabajo lo he hecho con mi compañera Chizlette.
Como os he dicho antes, este trabajo se trata de hacer una infografía donde tenemos que explicar datos importantes sobre el compositor que nos haya tocado y todo esto esta resumido en la infografía
Yogurt
Esta entrada hablare sobre un experimento que hemos hecho en clase con el yogurt.
Definición
Yogurt: producto lácteo de consistencia generalmente cremosa que se obtiene a partir de la fermentación de la leche.
Producida por bacterias, llamadas L. delbrueckii ssp. bulgaricus (bacilos) y S. salivarius ssp. thermophilus (cocos).
Química del yogurt
La composición química del yogurt cambia según el tipo de leche utilizada (leche entera de vaca, de cabra, de oveja, o de otros animales) y según la adición de sustancias aromatizantes o de fruta. Los ingredientes y el modo de elaboración determinan los tipos de yogur: líquidos, cremosos, desnatados, con frutas, etcétera.
Las vitaminas más importantes contenidas en el yogurt son la vitamina A, B1, B2, B6, B12, C, D, I. Los principales minerales son el calcio, el fosforo, el potasio y el sodio. El yogurt preparado con leche de vaca parcialmente descremada (o desnatada) contiene 88,50% de agua, 3,50% de proteínas, 1,80% de lípidos, 5,00% de glúcidos y un aporte energético de 49 Kcal cada 100 gramos.
Las vitaminas más importantes contenidas en el yogurt son la vitamina A, B1, B2, B6, B12, C, D, I. Los principales minerales son el calcio, el fosforo, el potasio y el sodio. El yogurt preparado con leche de vaca parcialmente descremada (o desnatada) contiene 88,50% de agua, 3,50% de proteínas, 1,80% de lípidos, 5,00% de glúcidos y un aporte energético de 49 Kcal cada 100 gramos.
Desinfección y esterilización
Se denomina desinfección a un proceso físico o químico que mata o inactiva agentes patógenos tales como bacterias, virus y protozoos impidiendo el crecimiento de microorganismos patógenos en fase vegetativa que se encuentren en objetos inertes.
Esterilización, acción y efecto de esterilizar. Este verbo se refiere a la acción de destruir los gérmenes patógenos o de hacer estéril e infecundo algo que antes no lo era.
Técnicas de esterilización de la leche
Pasteurización: este procedimiento consiste en calentar la leche a una temperatura aproximada de 80ºC, durante un corto periodo de tiempo y después enfriar rápidamente.
UHT (Ultra High Temperature): este procedimiento consiste en una inyección de vapor a presión durante menos de un segundo, hasta alcanzar los 150 ºC, con el fin de destruir los gérmenes.
UHT (Ultra High Temperature): este procedimiento consiste en una inyección de vapor a presión durante menos de un segundo, hasta alcanzar los 150 ºC, con el fin de destruir los gérmenes.
¿Cómo hemos producido yogurt a partir de leche no esterilizada y de leche esterilizada?
Producimos leche esterilizada, calentándola, ya que es una forma tradicional de esterilizarla y la que no está esterilizada.
Fotos:
Suscribirse a:
Comentarios (Atom)